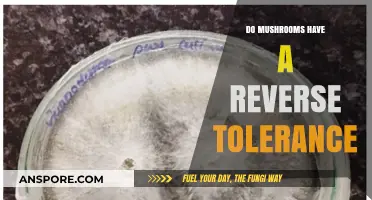
Mushrooms and Reverse Tolerance: Unraveling the Psychedelic Experience Mystery

Mushrooms and fish are a culinary pairing that has intrigued chefs and food enthusiasts alike, offering a unique blend of earthy and oceanic flavors. The umami-rich profile of mushrooms complements the delicate taste of fish, creating a harmonious balance that elevates both ingredients. Whether sautéed, grilled, or incorporated into sauces, mushrooms add depth and texture to fish dishes, making them a popular choice in various cuisines worldwide. From classic combinations like mushroom-stuffed trout to innovative recipes featuring exotic mushroom varieties, this duo showcases the versatility and sophistication of culinary pairings. Exploring how mushrooms enhance fish dishes not only highlights their compatibility but also inspires creative approaches to seafood preparation.
| Characteristics | Values |
|---|---|
| Flavor Pairing | Mushrooms complement fish with their earthy, umami flavor, enhancing the delicate taste of fish. |
| Texture | Mushrooms add a meaty, chewy texture that contrasts well with the flakiness of fish. |
| Culinary Usage | Commonly used in dishes like mushroom-crusted fish, fish stews, and seafood risottos. |
| Nutritional Synergy | Both are rich in protein, vitamins, and minerals, making the combination nutritionally balanced. |
| Popular Combinations | Salmon with shiitake mushrooms, cod with porcini, and trout with chanterelles. |
| Cooking Methods | Sautéed, grilled, or baked mushrooms pair well with similarly cooked fish. |
| Cultural Dishes | Found in French, Italian, and Asian cuisines, such as coq au vin with fish or mushroom-based broths. |
| Health Benefits | Low in calories and high in antioxidants, supporting heart health and immunity. |
| Seasonality | Fresh mushrooms and fish are often available year-round, making the pairing versatile. |
| Sustainability | Both can be sustainably sourced, aligning with eco-friendly culinary practices. |
Explore related products
$9.03 $9.73
What You'll Learn
- Mushroom-Fish Flavor Pairings: Earthy mushrooms complement mild fish like cod or tilapia, enhancing umami flavors
- Cooking Techniques: Sautéed mushrooms pair well with grilled fish; avoid overpowering delicate fish textures
- Sauce Combinations: Creamy mushroom sauces work best with rich fish like salmon or halibut
- Regional Dishes: Mediterranean and Asian cuisines often combine mushrooms with fish for balanced meals
- Health Benefits: Mushrooms and fish together provide protein, vitamins, and omega-3s for a nutritious dish

Mushroom-Fish Flavor Pairings: Earthy mushrooms complement mild fish like cod or tilapia, enhancing umami flavors
To maximize the umami effect, consider using shiitake or porcini mushrooms, which have a more intense savory profile. These varieties work particularly well with tilapia, another mild fish that benefits from the mushrooms’ robust flavor. A simple preparation, such as pan-searing the fish and serving it atop a bed of garlic-sautéed mushrooms, allows both ingredients to shine. Adding a splash of white wine or lemon juice during cooking can brighten the dish, cutting through the richness of the mushrooms while enhancing the fish’s freshness.
Incorporating mushrooms into fish dishes also offers versatility in cooking methods. Grilling or baking fish with a mushroom stuffing or topping is another excellent way to merge these flavors. For example, a mixture of chopped mushrooms, breadcrumbs, and herbs can be stuffed into a whole tilapia or cod fillet before baking. The mushrooms not only add flavor but also keep the fish moist and tender. This technique is particularly useful for lean fish that can dry out easily.
For a more elegant presentation, consider a mushroom sauce to accompany the fish. A creamy mushroom sauce, made with butter, shallots, and a variety of mushrooms, pairs beautifully with cod or tilapia. The sauce’s richness complements the fish’s mildness, creating a luxurious yet balanced dish. To keep it light, opt for a broth-based mushroom sauce instead, infused with thyme or parsley for added freshness.
Finally, don’t overlook the role of seasoning in enhancing mushroom-fish pairings. Simple seasonings like salt, pepper, and a touch of garlic allow the natural flavors of both ingredients to take center stage. For a bolder twist, incorporate soy sauce or miso paste, which further amplify the umami connection between mushrooms and fish. Whether you’re preparing a quick weeknight dinner or a sophisticated meal, mushroom-fish flavor pairings offer a delightful way to elevate your culinary creations.
Turkey Tail Mushrooms: Safe Superfood?
You may want to see also

Cooking Techniques: Sautéed mushrooms pair well with grilled fish; avoid overpowering delicate fish textures
When considering the pairing of mushrooms with fish, the cooking technique plays a pivotal role in ensuring the flavors complement each other without overwhelming the delicate nature of the fish. Sautéed mushrooms are particularly well-suited for this purpose, as their earthy and umami-rich profile enhances the natural taste of grilled fish. To achieve this harmony, start by selecting the right type of mushrooms—button, cremini, or shiitake mushrooms work well due to their versatility and robust flavor. Heat a pan over medium heat, add a tablespoon of olive oil or butter, and sauté the mushrooms until they are golden brown and slightly caramelized. This process not only develops their flavor but also ensures they retain a pleasant texture that contrasts nicely with the tenderness of the fish.
The key to pairing sautéed mushrooms with grilled fish is to avoid overpowering the delicate fish textures. Grilled fish, especially white-fleshed varieties like cod, halibut, or sole, has a subtle flavor and flaky consistency that can easily be overshadowed by heavy or overly assertive ingredients. To prevent this, season the mushrooms lightly with salt, pepper, and a touch of garlic or thyme, ensuring the flavors remain balanced. Additionally, avoid adding too much liquid during the sautéing process, as excess moisture can dilute the mushroom’s flavor and create a soggy texture that clashes with the dryness of grilled fish.
Another important consideration is the timing of the cooking process. Grill the fish just before serving to maintain its moisture and texture, while the sautéed mushrooms can be prepared ahead of time and kept warm. This ensures the fish remains the star of the dish, with the mushrooms acting as a supporting element. When plating, arrange the grilled fish on a bed of sautéed mushrooms or serve them alongside, allowing the flavors to meld together without one dominating the other. A drizzle of lemon juice or a sprinkle of fresh herbs over both components can further tie the dish together, enhancing the overall dining experience.
For those looking to elevate the pairing, consider incorporating a light sauce or glaze that bridges the flavors of the mushrooms and fish. A simple white wine or lemon butter sauce can be drizzled over both elements, adding a layer of sophistication without overpowering the dish. The acidity from the wine or lemon helps cut through the richness of the mushrooms, while the butter adds a velvety texture that complements the grilled fish. However, use this technique sparingly, as too much sauce can weigh down the dish and detract from the intended balance.
In summary, sautéed mushrooms pair exceptionally well with grilled fish when executed with care and attention to detail. By focusing on proper cooking techniques, seasoning, and presentation, you can create a dish where the earthy mushrooms enhance the delicate fish without overshadowing it. This approach not only highlights the natural flavors of both ingredients but also demonstrates the importance of balance in culinary pairings. Whether for a casual dinner or a special occasion, this combination is sure to impress with its simplicity and elegance.
Mushrooms: How Long Do They Last?
You may want to see also

Sauce Combinations: Creamy mushroom sauces work best with rich fish like salmon or halibut
Creamy mushroom sauces are a delightful pairing for rich, flavorful fish such as salmon or halibut. The earthiness of mushrooms complements the natural richness of these fish, creating a harmonious balance of flavors. When preparing a creamy mushroom sauce, start by sautéing a mix of wild mushrooms like shiitake, cremini, or porcini in butter until they release their moisture and develop a golden-brown color. This step enhances their umami flavor, which pairs exceptionally well with the fatty texture of salmon or halibut. Adding garlic and shallots to the sauté can further deepen the sauce’s complexity, providing a robust base that stands up to the fish’s bold taste.
To create the creamy element, incorporate heavy cream or a combination of cream and chicken or vegetable stock into the mushroom mixture. Simmer the sauce until it thickens slightly, ensuring it clings beautifully to the fish without overwhelming it. A splash of white wine or dry sherry during the cooking process can add brightness and cut through the richness, making the sauce more dynamic. Seasoning with fresh thyme, parsley, or a pinch of nutmeg can elevate the sauce, tying together the earthy mushrooms and the fish’s natural flavors.
When serving, spoon the creamy mushroom sauce generously over the cooked salmon or halibut, allowing it to meld with the fish’s juices. This combination works particularly well with pan-seared or baked fish, as the cooking methods retain the fish’s moisture and integrity. For added texture, consider topping the dish with crispy fried mushrooms or a sprinkle of breadcrumbs for contrast against the creamy sauce. The result is a luxurious, restaurant-quality meal that highlights the best of both the mushrooms and the fish.
Another variation to explore is incorporating cheese into the creamy mushroom sauce. A small amount of grated Parmesan or crumbled goat cheese can add a tangy, savory note that complements the richness of the fish. This approach is especially effective with halibut, as its mild flavor provides a perfect canvas for the sauce’s complexity. Pairing the dish with sides like roasted asparagus, mashed potatoes, or a simple green salad ensures the sauce remains the star while keeping the meal balanced.
Finally, consider the presentation to enhance the dining experience. Arrange the fish on a plate with the creamy mushroom sauce cascading over it, and garnish with fresh herbs or a drizzle of truffle oil for an extra layer of indulgence. This sauce combination not only elevates the fish but also transforms the meal into a sophisticated culinary experience. By focusing on the interplay between the creamy mushrooms and the rich fish, you can create a dish that is both comforting and elegant, proving that mushrooms and fish are indeed a match made in culinary heaven.
White Button Mushrooms: Nature's Decomposing Superheroes
You may want to see also
Explore related products

Regional Dishes: Mediterranean and Asian cuisines often combine mushrooms with fish for balanced meals
In Mediterranean cuisine, the combination of mushrooms and fish is a testament to the region’s emphasis on fresh, seasonal ingredients and balanced flavors. One standout dish is Greek Psari me Manitaria, where white fish like cod or sea bass is baked with a mixture of wild mushrooms, olive oil, garlic, and herbs such as oregano and dill. The earthiness of the mushrooms complements the delicate flavor of the fish, while the olive oil and lemon juice add brightness. This dish is often served with a side of roasted vegetables or a simple salad, embodying the Mediterranean principle of wholesome, nutrient-dense meals. Similarly, in Italian cuisine, Branzino con Funghi pairs sea bass with porcini or shiitake mushrooms, sautéed in white wine and finished with parsley and a squeeze of lemon. The umami-rich mushrooms enhance the fish’s natural sweetness, creating a harmonious and satisfying dish.
Asian cuisines also excel in combining mushrooms and fish, often using techniques that highlight umami and texture. In Japanese cooking, Mushroom and Salmon Hot Pot (Kinjirno Nabe) is a popular winter dish where slices of salmon and shiitake or enoki mushrooms are simmered in a dashi-based broth with tofu, leeks, and other vegetables. The mushrooms absorb the savory broth while adding depth to the mild salmon, resulting in a comforting and balanced meal. Another example is Chinese Steamed Fish with Shiitake Mushrooms, a Cantonese classic. Here, a whole fish like sea bass or snapper is steamed with shiitake mushrooms, ginger, scallions, and soy sauce. The mushrooms’ earthy flavor melds with the fish’s natural juices, creating a light yet flavorful dish that is both healthy and elegant.
In Southeast Asia, the pairing of mushrooms and fish often involves bold flavors and aromatic spices. Thai Fish Curry with Straw Mushrooms combines firm white fish like cod or catfish with straw mushrooms in a coconut milk-based curry flavored with lemongrass, galangal, and chili. The mushrooms add a chewy texture and earthy undertone that balances the curry’s richness and heat. Similarly, in Vietnamese cuisine, Canh Chua Ca (sour fish soup) sometimes includes button or oyster mushrooms alongside fish, pineapple, and tomatoes in a tamarind-infused broth. The mushrooms contribute to the soup’s complexity, enhancing its umami while complementing the fish’s freshness.
These regional dishes demonstrate that mushrooms and fish are a natural pairing, offering a balance of flavors, textures, and nutritional benefits. Whether baked, steamed, simmered, or stir-fried, the earthiness of mushrooms enhances the delicate nature of fish, while the fish’s lightness prevents the dish from becoming too heavy. Both Mediterranean and Asian cuisines leverage this synergy to create meals that are not only delicious but also aligned with principles of balance and harmony. By incorporating seasonal mushrooms and fresh fish, these dishes showcase the versatility of this combination across diverse culinary traditions.
For home cooks inspired by these regional dishes, the key is to choose mushrooms and fish that complement each other in flavor and texture. Firm, white-fleshed fish like cod, sea bass, or snapper pair well with hearty mushrooms such as porcini, shiitake, or cremini, while more delicate fish like sole or trout can be matched with milder varieties like enoki or oyster mushrooms. Cooking methods such as baking, steaming, or simmering allow the flavors to meld gently, while finishing touches like herbs, citrus, or spices add brightness and depth. Whether drawing from Mediterranean or Asian traditions, combining mushrooms and fish is a sure way to create balanced, flavorful, and memorable meals.
The Best Ways to Split Mushrooms
You may want to see also

Health Benefits: Mushrooms and fish together provide protein, vitamins, and omega-3s for a nutritious dish
Combining mushrooms and fish in a dish not only creates a flavorful culinary experience but also offers a powerhouse of health benefits. Both ingredients are nutrient-dense, making them an excellent choice for those seeking a balanced and nourishing meal. Protein is a standout benefit of this pairing. Fish, particularly varieties like salmon, cod, or tuna, is a lean source of high-quality protein, essential for muscle repair, immune function, and overall body maintenance. Mushrooms, while not as protein-rich as fish, still contribute to the overall protein content of the dish, especially when using varieties like shiitake or portobello, which have a meatier texture and higher protein levels. Together, they provide a complete protein profile that supports satiety and energy levels.
In addition to protein, this duo is a vitamin-rich combination. Fish is an excellent source of vitamin D, which is crucial for bone health, immune function, and mood regulation. It also contains vitamin B12, essential for nerve function and DNA synthesis. Mushrooms, on the other hand, are one of the few natural food sources of vitamin D, especially when exposed to sunlight or UV light during cultivation. They also provide B vitamins, including riboflavin, niacin, and pantothenic acid, which support energy production and skin health. Together, mushrooms and fish create a meal that helps meet daily vitamin requirements, promoting overall well-being.
Another significant health benefit of pairing mushrooms and fish is their combined omega-3 fatty acid content. Fatty fish like salmon, mackerel, and sardines are renowned for their high levels of omega-3s, which are anti-inflammatory and support heart, brain, and joint health. While mushrooms do not contain omega-3s, they complement fish by providing other beneficial compounds like antioxidants and beta-glucans, which boost immune function and reduce inflammation. This synergy makes the dish not only heart-healthy but also supportive of long-term health and disease prevention.
Furthermore, mushrooms and fish together contribute to a low-calorie, nutrient-dense meal, ideal for weight management and overall health. Fish is a lean protein source, low in calories but high in essential nutrients, while mushrooms add volume, flavor, and fiber to the dish without significantly increasing caloric intake. The fiber in mushrooms aids digestion and promotes gut health, while the minerals in both ingredients, such as selenium, zinc, and iodine, support thyroid function, metabolism, and immune responses. This combination ensures that the meal is both satisfying and nourishing.
Lastly, the versatility of mushrooms and fish allows for creative cooking methods that retain their nutritional value. Grilling, baking, or steaming preserves the integrity of their nutrients, ensuring that the health benefits are maximized. For example, a dish like baked salmon with sautéed mushrooms not only highlights their natural flavors but also delivers a concentrated dose of protein, vitamins, and omega-3s. Incorporating this pairing into your diet regularly can contribute to a healthier lifestyle, proving that mushrooms and fish are not just a delicious combination but also a nutritionally smart choice.
Mushrooms: Pollination Secrets of the Forest
You may want to see also
Frequently asked questions
Yes, mushrooms pair well with fish due to their earthy flavor, which complements the delicate taste of fish. They add depth and richness to dishes like grilled fish, seafood stews, or fish risotto.
Mild mushrooms like button, cremini, or shiitake work well with fish, as they enhance the dish without overpowering it. For a more robust flavor, porcini or oyster mushrooms can also be a great choice.
Mushrooms can be sautéed and served as a side, added to a sauce or stuffing, or used in a seafood stew or chowder. They can also be grilled or roasted alongside fish for a flavorful combination.